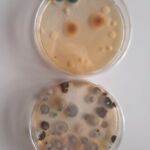

Galerijas
2025./2025.m.g.
2024./2025.m.g.
2023./2024.m.g.
2022./2023.m.g.
Padziļinātā bioloģijas stunda a/s “Smiltenes piens”
2021./2022.mācību gads
2020./2021.mācību gads
2019./2020.mācību gads
2018./2019.mācību gads
2017./2018.mācību gads
2016./2017.mācību gads